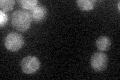
YAL023C
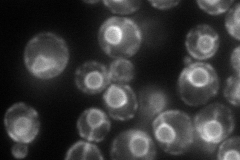
YAL023C
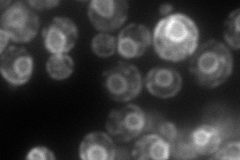
YAL023C
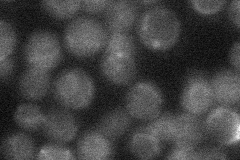
YAL023C
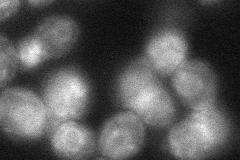
YAL023C
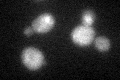
YAL023C

View description
Protein O-mannosyltransferase, transfers mannose residues from dolichyl phosphate-D-mannose to protein serine/threonine residues; acts in a complex with Pmt1p, can instead interact with Pmt5p in some conditions; target for new antifungals
Localization:
Intensity:
Fold change:
Significance:
-
C’ GFP library in SD
ER24.45 -
N' NOP1pr-GFP in SD
ER149.063 -
N' TEF2pr-mCherry in SD
ER132.693 -
N' NATIVEpr-GFP in SD
below threshold22.0207 -
N' TEF2pr-VC and Cyto-VN in SD
ER50.0761 -
C’ GFP library in SD+DTT
ER23.40.95No -
C’ GFP library in SD+H2O2

ER19.070.77Yes -
C’ GFP library in Starvation Media

ER17.240.7Yes -
C’ GFP library on the background of Pup2-DaMP

ER -
C’ GFP library on the background of CCT mutant

ER18.71470.765168No
